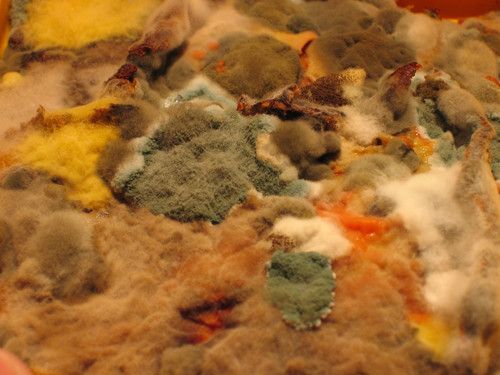

Learner-dependent answer.
Biodiversity
Chapter overview
3.5 weeks
After looking at the biosphere and where life exists on Earth, we will now look at the biodiversity of life on Earth. This chapter starts off with looking at the classification system and how scientists have classified all living organisms. This hierarchical classification system provides an overview and will be dealt with again in Gr. 10 if learners take Life Sciences. After looking at the five kingdoms, we will then look at the biodiversity of plants and animals. In CAPS, learners would have looked at the variety in plants and animals before in Gr. 5 and heard the term biodiversity. This is built upon and extended as we look at the different classifications of plants and animals. The other three kingdoms, namely Protista, Fungi and Bacteria are not dealt with in detail, but in Gr. 9, learners will again look at some examples when they do microorganisms in more detail.
2.1 Classification of living things (3 hours)
|
Tasks |
Skills |
|
|
Activity: Group some everyday objects |
Observing, classifying, group work, describing, discussing, recording, writing |
CAPS suggested |
|
Activity: Aristotle's classification system |
Observing, classifying, drawing, explaining |
Optional (Extension) |
|
Activity: Comparing plants and animals |
Observing, identifying, comparing, discussing |
CAPS suggested |
2.2 Diversity of animals (4.5 hours)
|
Tasks |
Skills |
|
|
Activity: Classifying vertebrates and invertebrates |
Identifying, classifying |
CAPS suggested |
|
Activity: Identify the five classes of vertebrates (Chordata) |
Identifying, classifying, remembering |
CAPS suggested |
|
Activity: Identify defining features of fish |
Observing, identifying, listing |
Optional (Suggested) |
|
Activity: Describing amphibians |
Observing, identifying, explaining, hypothesising |
Optional (Extension) |
|
Activity: Reflect on reptiles |
Drawing, labeling, identifying, classifying |
Optional (Extension) |
|
Activity: Identify characteristics of birds |
Group work, explaining, identifying, characterising, comparing |
Optional (Extension) |
|
Activity: Identify characteristics of mammals |
Group work, brainstorming, remembering, listing |
Optional (Extension) |
|
Activity: Comparing vertebrates |
Comparing |
Optional (Suggested) |
|
Activity: Classifying arthropods |
Observing, describing, classifying |
Optional (Extension) |
|
Activity: Observing molluscs |
Observing, identifying, describing, drawing, labeling |
CAPS suggested |
2.3 Diversity of plants (3 hours)
|
Tasks |
Skills |
|
|
Activity: Invasive plants in South Africa |
Observing, researching, describing |
Optional (Extension) |
|
Activity: Discovering the differences between monocotyledons and dicotyledons |
Observing, describing, summarising |
CAPS suggested |
- How do we group or classify all the living organisms in the world?
- Why do we need to group or classify living things?
- How can we classify all the animals on Earth?
- What is the difference between reptiles and amphibians?
- Are insects and arachnids (spiders) different?
- Is there a way to classify plants?
- What is the diversity of plants and animals in South Africa?
If possible, display a selection of nature magazines, books and reading materials in the class during the time that you go through this chapter. You can collect photos or pictures from magazines of many different plants and animals, fungi and bacteria. A suggestion is to cover them in plastic, in order to reuse them in subsequent years.
Over millions of years each species living today has changed and adapted to live in a specific type of environment in order to ensure the survival of that species. Biodiversityis a term used to describe the great variety of living organisms on Earth and their varied habitats.
There are just so many types of organisms. How can we make sense of all the organisms on Earth? We need some way to group them. This is called classifying. Let's find out how we do this!
Classification of living things
- characteristic
- class
- classify
- kingdom
- order
- phyla
Grouping has been a common activity in humans for thousands of years as we make sense of the world around us.
Group some everyday objects
In this activity learners will get an opportunity to group a selection of everyday objects according to observable features. This lays the foundation for the classification and grouping work that is covered in this section. Teachers should collect enough shoeboxes or recycled ice-cream tubs (or if this is not possible shopping bags should also work) for each of the groups in the class. As homework the previous day each learner needs to bring five items from home. These items should be small enough to go into the shoebox. They should choose items that they use in their everyday lives. Please ensure that no valuables are brought!
MATERIALS:
- objects from home
- shoe boxes/ ice-cream tubs
When you observe you use your senses to tell you more about something. How does it feel or look? Does it have a special smell or taste? Is there a specific sound coming from it?
INSTRUCTIONS:
- Work in groups of four.
- Each member of the group should bring five items from home. Choose items that are easy to carry around and that will fit into a standard shoe box.
- Carefully observe each of the items that everyone in your group brought.
- Use the shoe boxes to group the items according to your observations.
- Place all objects brought by the whole class on a display table in the front of the class.
-
Discuss the different grouping methods that each group has used as a class. Work towards a standard grouping or classifying method that you could use to classify ALL the items that you all brought to school.
During this activity, encourage learners to look at the observable features of the items in order to classify them, for example shape, colour, size, texture, use etc.
QUESTIONS:
Learner-dependent answer.
Write three or four sentences about the standard classification method that you decided to use in your class. What characteristics of the items did you use to classify and group them? Were these different to what you used in your small group?
Learner-dependent answer.

Aristotle was a Greek philosopher and thinker who lived about 2400 years ago. Aristotle came up with the following grouping system that was used for almost 2000 years after his death!
- He divided all organisms into either animals or plants.
- Then he divided animals into those 'with blood' and those 'without blood'.
- Lastly animals are divided into three groups based on their method of movement: walkers, flyers or swimmers.
Aristotle's classification system
This is an optional activity to introduce different types of classification.
INSTRUCTIONS:
- Look at the following photos of different kinds of animals.
- Use Aristotle's method of classification to group the animals based on the way that they move.
- Draw a table of your groupings in the space provided after the photos. Give your table a heading.









Learner-dependent answer. The table should look as follows. There may be some variations depending if learners decide to put an animal in more than one group or classify it according to its main method of movement.
Classification of a group of animals according to Aristotle's method
|
Walkers |
Flyers |
Swimmers |
|
Penguin Elephant Cat Crocodile Human |
Eagle Butterfly Bats |
Penguin Dolphins Crocodile Human |
QUESTIONS:
Difficult animals to classify are those which can fall into more than one group, such as the penguin, crocodile, human.
Possible answers might include: Some animals fit into more than one group (penguin, crocodile, etc.) because it looks more at what the animals do rather than what they are or similarities and differences between their forms.
As more and more animals, plants and microorganisms were discovered, scientists started questioning Aristotle's classification system. It was not working as well as everyone had believed it would. Why do you think it is important to evaluate how we classify things?
Discuss this as a class. Refer to this process as being a constant refining of the way that classification is done and that it is not a 'given' or a static method. It needs to evolve as our knowledge and understanding of the world and the organisms in it develops and must take these new discoveries into account.

In the 1700s Carl Linnaeus developed the classification system that classified organisms according to their similarities, functions and relationships with other organisms.
Today with the use of modern microscopes and genetics we can classify living organisms very accurately. In this way we are able to classify living organisms according to their shared characteristics.
Scientists estimate that there are up to 30 million species of organisms on Earth! If they use systems to classify these organisms they can see patterns in nature and can see how organisms relate to each other.
Our classification system
All living organisms can be divided into five kingdoms:
-
Animals
-
Plants
-
Fungi
-
Protists
-
Bacteria

What are humans? Which kingdom do we belong to?
Since we know that we are not a fungi or plant, or a protista or bacteria (quite a bit bigger!) we belong to the animal kingdom.
The kingdom Bacteria is often also referred to as Monera.
Think back to the example of how we classify learners at school. First, school is divided into pre-primary school, primary school and high school. If we compare school to the way we classify organisms, we can say that the school system has three kingdoms. But, we need to divide learners up further. So primary school is divided into seven grades (Gr. 1-7) and high school is divided into five grades (Gr. 8-12). The classification system for organisms also needs to divide organisms up further as each kingdom contains thousands of different types of organisms.
Each kingdom is divided into smaller groups or divisions called phyla. Organisms with similar traits (characteristics) will occupy a similar phylum. In each phylum, smaller divisions called classes are found and each class is further divided into orders, families, gen eraand thenspecies.
Be careful to use these words correctly: one phylum, many phyla. Similarly, one genus, many genera.
Think of your school again. Your primary school contains many learners. When you divide your entire school into grades, there are fewer learners in each grade. Your grade might be divided into different classes, and each class has fewer learners in it. When we classify organisms, the same thing happens. A kingdom is a very big group, whereas a species is a much smaller group.
Study this diagram to help you remember the order:

A mnemonic takes the first letters of a group of terms to make a funny rhyme.
King Phil Cuts Open Five Green Snakes
An interactive game on classifying animals http://sciencenetlinks.com/interactives/class.html
We need to be able to distinguish between organisms too. So how do we name organisms?
Binomial comes from the Latinbi- two and nomius- names. Nomenclature comes from Latin words nomen - name and calare- to call. Binomial nomenclature therefore means calling things by two names.
Carl Linnaeus designed a special naming system called the binomial nomenclature to name all organisms. All organisms are therefore given two (bi- means two) words in their name.
- The first part of the name refers to the genus that the organism belongs to. This is always written with a capital letter.
- The second part of the name refers to the species within the genus
-
If you are typing you will put both these names in italics but if you are doing a handwritten piece you underline it. This shows that you are identifying the organism by its scientific name.
For example, the scientific name for the African elephant is Loxodonta africana. Humans belong to the genus Homo and to the species sapiens so we are Homo sapiens.
The 'scientific name', the 'Latin name' and 'binomial nomenclature' are different ways of saying the same thing. All of these are referring to thesame system of naming a species by its genus and species names in Latin.
Have a look at some curious and strange names for organisms http://www.curioustaxonomy.net/index.html
Now that we have seen how to classify organisms, let's take a closer look at the differences between the kingdoms.
Plants and animals
The phylogame (a card game which could be played in class) http://phylogame.org/
Comparing plants and animals
INSTRUCTIONS:
- Study the diagram that shows the five kingdoms that we commonly use to classify organisms. Pay close attention to the plants and animals.
- Answer the following questions.
When we compare plants and animals we can often compare them based on the way that they move, what and how they get food or nourishment, and how they reproduce.
QUESTIONS:
Learner-dependent answers. Might include: all these animals can move using a variety of methods or that all might have a special body covering. These animals all have to eat, either plants or other animals. They generally reproduce by mating with other animals of the same species. Animals drink water. Animals respire as they take in oxygen and give off carbon dioxide, often through breathing. Animals need to excrete their waste from their bodies.
Learner-dependent answers. Might include: plants cannot move, they are rooted to one spot. Plants do not need to eat as they produce their own food by photosynthesis. They take in water. Plants also respire like animals but they also take in carbon dioxide for photosynthesis and give off oxygen as a by product. Plants' reproduction differs to animal reproduction in that many plants produce seeds while others produce other structures (like ferns) etc.
Draw a table in the space below and compare the characteristics of plants that make them different to animals. Discuss your plant and animal comparisons with your group and then with the class.
Learners should compare the observable differences on the diagram / illustration between plants and animals. Some of these might include:
|
Plants |
Animals |
|
Plants are generally rooted in one place and move by growing in shape and turning their leaves or petals towards the sun or a water source. |
Animals can self-propel (move themselves around) through locomotion in order to find food, a mate or shelter, or to evade danger. |
|
Plants that contain chlorophyll can photosynthesize to produce glucose (food) from sunlight and carbon dioxide. |
Animals cannot produce their own food and have to eat plants or other animals to get nourishment. |
|
Plants produce oxygen and take in carbon dioxide. |
Animals take in oxygen and produce carbon dioxide. |
|
Plants have a limited ability to sense. |
Animals have a well-developed ability to sense. |
|
etc. |
etc |
Learn more about the kingdom Animalia
Fungi
Most people will not eat bread covered in bread mould but will eat a plate of fried mushrooms, truffles and morels. These are all examples of fungi, including yeast.
Morels are a type of edible mushroom. They are distinctive for the appearance of their caps, which are have pits and ridges that resemble a honeycomb.

You can find out lots more online by visiting the links provided in theVisit boxes. Be curious and discover the possibilities!
Fungi play a very important role in our biosphere since they break down dead organic material and return nutrients to the soil for plants to use. Some fungi cause diseases while others, such as penicillin (an antibiotic) are very useful to us. Yeast is used in many of our products, such as making bread rise and fermenting wine and beer.
Protists and Bacteria
Learners will only be able to fully understand the differences between Protists and Bacteria once they have done cells in Gr. 9. Essentially, Protists are eukaryotic (usually unicellular, but not always) as they have cells with a membrane bound nucleus, whereas Bacteria are prokaryotic as their DNA material is not membrane bound. Bacteria are always unicellular. Protists require a liquid medium, whereas Bacteria occur almost everywhere.
We will look at Protists and Bacteria in more detail later on in Gr. 9. For now, lets look at some of the basic features of these kingdoms.
Organisms in these two kingdoms are microscopic which means you cannot see them with your naked eye. However we can see them if we look at them under a microscope.
These images are included to give learners some idea about these two kingdoms, otherwise they will have no reference point until they get to Gr. 8 and do microorganisms again. These images are also interesting and show what is possible with the microscopy techniques available today. They include a range of techniques from scanning electron microscopy, confocal, fluorescent and light microscopy. The differentiation of a membrane bound nucleus in Protists and not in Bacteria is too advanced for learners at this stage if they have not yet done cells. For now, encourage learners to look at the photos, perhaps ask them to explain what they see, and let them get excited about the unseen world! Learners do not need to know how to recognise or name any of these microorganisms.
Different bacteria:




Different Protists:




Now we will look at the amazing diversity of animals and plants on Earth, and especially in South Africa.
Diversity of animals
- diversity
- invertebrate
- vertebrate
Provide learners with old magazines and ask them to cut out any and all animals that they see. (If you teach this lesson a few years running it is worth the effort and money to cut their animals out carefully and have these laminated then they can be used over and over again!) When they have collected a large quantity of animals ask them to group the animals into only two groups. Encourage them to manipulate the animals and transfer them from one group to another, and encourage positive debate about their groupings and why they chose those specific groupings. Then end result should be that there are two main groups of animals, and scientifically speaking these would hopefully be vertebrates and invertebrates, or alternatively those with feathers and those without; those with mammary glands and those without, those with wings and those without, etc. As learners work with the pictures make sure to model words like observe, compare, contrast, evaluate, etc.
Some learners might ask "WHY" we classify and they should be praised for doing this. If this occurs point out to them that classification helps us to sort out ancestor / descendent relationships and we are therefore able to track the evolutionary history of all living organisms.Thus the presence or absence of one specific characteristic might show that an organism is related to others in in a specific genus, family or order and can also guide an investigation into the evolutionary history of these organisms. Many learners might for instance be unaware that lions, rhino and elephants are indigenous to Africa but are also found naturally in other parts of the world, like India, and through classification we are able to see how the Black Buck and the Koedoe, or the One-horned Rhinoceros of Asia and the South African black rhino are related.
Classifying animals
All the animals in the world form part of the animal kingdom.There are two distinct divisions or groups of animals within the animal kingdom: the vertebrates and the invertebrates. Can you remember what is used to classify an animal as a vertebrate or invertebrate? Look at these x-rays of animals for a clue.
The presence or absence of a backbone is used to classify animals as vertebrates or invertebrates. The dolphin, dog and goose are vertebrates and the grasshopper and crab are invertebrates.

Almost 98% of all the animals that have been discovered on Earth are invertebrates!
Animals that have a backbone with a hollow tube inside to hold the nerves are vertebrates. As we can see in the x-ray images of the dolphin, dog and goose, we can see the skeletons of these vertebrates. They are made of bone. We say that vertebrates have an endoskeleton.
What about the grasshopper and the crab? Why can we not see their bones? This is because invertebratesdo not have a skeleton made of bones. The grasshopper and crab have a hard shell covering on the outside of their bodies. This supports their soft bodies inside. We say they have an exoskeleton. But not all invertebrates have an exoskeleton.
What about a jellyfish? It does not have a backbone, so it is not a vertebrate, so it must be an invertebrate. Does it have a hard, outer covering called an exoskeleton? Discuss this with your class. Make sure to take note of the third type of skeleton in your discussion.
Invertebrates do not have a backbone, but this does not necessarily mean that they have an exoskeleton. Many invertebrates have a hydrostatic skeleton, like the jellyfish and earthworm. Some invertebrates such as like the snail and have an exoskeleton (shell) and a hydrostatic skeleton. Sponges actually have a type of endoskeleton as their 'skeletons' are made of calcareous spicules.
Classifying vertebrates and invertebrates
INSTRUCTIONS:
In the table identify the type of skeleton that each animal has and write it down beneath each picture.
Write down whether the animal is an invertebrate or a vertebrate.
A useful chart showing the classification system http://www.usefulcharts.com/science/classification-of-animals-chart.html
'Phylum' is the singular and 'phyla' is the plural use of the word.
The invertebrates are divided into five phyla. The invertebrate phyla are:
- Sea sponges
- Jellyfish
- Roundworms
- Molluscs
- Arthropods
The five phyla making up the invertebrates have scientific names, but these are not necessary to know at this stage. We will only focus on the two phyla Arthropoda and Mollusca.
Vertebrates belong to the phylum Chordata. Vertebrates are subdivided into five classes.
Only about 2% of all the animals on Earth have a backbone.
Have a look at the following diagram which shows the different classes of vertebrates and phyla of invertebrates. Remember, all vertebrates belong to the phylum Chordata.

Identify the five classes of vertebrates
INSTRUCTIONS:
- Study the previous chart showing vertebrates and invertebrates and identify the names of the five classes of vertebrates. Write these on the lines below.
- Use the pictures that you previously collected from magazines to find at least 5 examples of each of these classes of animals.
QUESTIONS:
Identify at least one distinguishing characteristic that each class shares or has in common (that makes that class different from other classes.) Write this on the line next to the classes that you identified above.
- Fish - scales / gills / fins / etc
- Amphibians - soft moist skin / lungs and skin used for breathing / four limbs with webbed feet
- Reptiles - scaly skin / lungs used for breathing / four limbs with toes
- Birds - beak, feathers cover body / air sacs used for breathing / two scaly legs and two wings,
- Mammals - fur or hairy skin / lungs / four limbs / mammary glands, live birth
Since many animals in Africa are under threat due to habitat loss and poaching the animals featured in this section were specifically included to raise awareness and to expose learners to the wonderful animals living in South Africa. Teachers are encouraged to work with teachers from other subjects, such as the languages or art, to let learners make anti-poaching or awareness campaign posters to address the environmental issues and raise awareness with other learners in the school.
Vertebrates
- amphibian
- cartilage
- ectothermic
- endothermic
- gill
- larva / larvae
- mammary gland
The five classes of vertebrates are:
- Fish
- Amphibians
- Reptiles
- Birds
- Mammals
Fish
Visit http://school-of-fish.co.uk/teacher_resources_topic.php for a teachers' support website on fish.
Fish come in all sorts of shapes, sizes and colours. There is huge diversity amongst fish. Have a look at some of the following drawings of different types of fish.






Unusual and weird deep sea fish (video)
Identify defining features of fish
QUESTIONS:
Features learners might list include: ectothermic, backbone, fins, gills, scales, living in water, breathing oxygen from water, streamlined body, lay eggs.
The combination of gills, fins and the fact that fish live only in the water are the main defining characteristics of fish and make fish different from all other animals.
When classifying fish we look closely at the material that makes up the skeleton of the fish. This leads us to divide fish into two main groups:
-
Cartilaginous fish have skeletons made of cartilage.
-
Bony fish that have skeletons made of bone.
An ancient fish-like class of animals are called Agnatha. Hagfish and Lampreys are part of this group. Hagfish for instance look more like worms than fish. There is controversy over whether hagfish should be classified as fish or not.
Interesting article on the use of hagfish slime to make clothing! http://www.bbc.co.uk/news/magazine-21954779
Sharks, skates and rays are part of a group of cartilaginous fish because their skeletons are made of cartilage. These fish breathe using five to seven pairs of gills.
Two thirds of the sharks brain is dedicated to its sense of smell. A shark's sense of smell is so well developed that it can tell the direction from which a smell is coming.




A whale shark is a shark and not a whale. It is the world's largest fish and it eats only plankton.
The coelacanth was thought to be extinct for 65 million years, but was discovered in a catch of fish in 1938. Since then, more have been found along the coast of Southern Africa.
The largest group of all vertebrates are bony fish. Bony fish have a hard, bony skeleton.
Challenge question: Is a seahorse a fish? Search books and the internet to find out and explain why we can or cannot consider it to be a fish.

Yes a sea horse is in fact a fish. It breathes with gills, has a swim bladder to control buoyancy and a spine, and even though they don't have a tail fin they have four other fins that help them move. Unlike most fish, sea horses do not have scales, but skin.
The male seahorse actually becomes pregnant! The female squirts her eggs into the male's pouch and he then fertilizes them and incubates them until they are ready to hatch.
Watch this video of a male seahorse giving birth
Amphibians
Did you know that the word amphibia comes from two Greek words, amphi meaning both and bios meaning life? So an amphibian is an animal that has 'both lives'. What does this mean?
Amphibians are animals that include salamanders, newts, caecilians, frogs and toads. Let's find out what is meant by amphibians having 'both lives'.
A group of birds is called a flock, a group of cattle is called a herd, a group of lions is called a pride, but a group of frogs is called an army.
Describing amphibians
INSTRUCTIONS:
- Study the photos of different amphibians in the following table.
- Answer the questions which follow.
|
Amphibian |
Larva (young) |
Adult |
|
Frog |
 |
 |
|
Toad |
 |
 |
|
Salamander |
 |
 |
|
Newt |
 |
 |
Salamanders can regenerate (regrow) their limbs and tail within a few weeks if they were lost due to predator attacks.
QUESTIONS:
The young larvae are all in water whereas the adults are on land or near water.
What do you think the larvae need to breathe underwater? What do the adult amphibians need to breathe when they are on land?
The larvae needs gills to breathe in water, the adults have lungs to breathe on land.
Amphibians have two stages in their life cycle. First, they have the larval stage where they are in water, and then they have the adult stage where they live on land (and also in or near water).
Amphibians are ectothermic. Explain how an amphibian keeps its body warm.
They get heat from their environment and therefore need to live in areas where it is warm enough for them to have enough body heat to survive. If it gets very cold an amphibian will need to either find a space under a log or leaves, or else sit in the sun.
Learners need to compile a plausible explanation or hypothesis. The correct explanation is: Glands in the skin secrete liquid to keep the skin slimy and moist as frogs may need to use the skin alongside the lungs and mouth for gaseous exchange.
Look at the following image of a caecilian. There is a debate going on in a Gr. 6 class. Some learners think this animal is a worm, making it an invertebrate. Others think it is a snake, making it a vertebrate. What do you think?

The caecilian is actually an amphibian! What characteristics would you test or make sure this animal displayed to explain to the Gr. 6 learners that it is not a worm. Secondly, what would you need to find out and explain to the learners to explain that it is not a reptile (a snake) but an amphibian?
In order not to be an invertebrate, like a worm, the animal needs to have a backbone. The caecilian does have a backbone and a skull. The caecilian is not a snake (it is not a reptile) as it has a larval stage which is born in water and it undergoes metamorphosis to become the adult caecilian. The larvae also have gills to breathe underwater. Caecilians also do not have scales like reptiles.
Amphibians lay their eggs in water, like this frog. Why do you think they need to do this? Give two reasons.

Some possible reasons are: The eggs are in water so that when the larvae hatch they are already in the water to swim around, the eggs would dry out if they were not in water, the fertilisation process in amphibians often requires water as the female will lay the eggs and as she does so, the male deposits his sperm is the water around them so they are fertilised.
You can tell the difference between frog eggs and toad eggs because frogs lay their eggs in clumps and toads lay their eggs in strings. Have you ever seen frog or toad eggs?
Interesting article on caecilians http://www.sciencenewsforkids.org/2012/05/caecilians-the-other-amphibian/
Metamorphosis: Amphibians (full documentary).
Reptiles
Reptiles have survived on Earth for millions of years. The first reptiles on earth lived 310 to 320 million years ago and included the dinosaurs.
Learn about a fascinating reptile found in Australia called the thorny dragon http://www.wild-facts.com/tag/thorny-dragon/
Most reptiles live on land although some, like crocodiles, terrapins and turtles, and some snakes and lizards spend large portions of their lives in water. Reptiles are ectothermic. They cannot regulate their body heat but depend on their environment for heat.

Reptiles are covered in dry scales. Reptiles reproduce by laying their eggs on dry land. The eggs are covered by a leathery or hard shell.
Learn more about the boa constrictor which keeps its eggs inside its body until they are ready to hatch http://www.theanimalspot.com/boaconstrictor.htm
Reflect on reptiles
QUESTIONS:
- Since reptiles all have a backbone they are one of the classes of ______.
- Reptiles are ectothermic which means that ______.
- chordata or vertebrates
- they cannot regulate their body temperature but depend on their environment for heat
Make a biological drawing with labels and a heading of the lizard lying in the sun in the previous photo.
Learner-dependent answer

We can divide reptiles into four main groups. Each of the photos in the table below shows an example of a reptile from each of these groups. Try to identify the four groups based on the animal in the photo.
 |
 |
 |
 |
 |
 |
|
crocodiles and alligators |
lizards and geckos |
 |
 |
|
snakes |
turtles, terrapins and tortoises |
Turtles are only found in the sea, terrapins are found in freshwater, and tortoises do not swim around, but walk on land.
Birds
If possible, take your learners outside before you start discussing birds to see if you can spot any in the school grounds. Ask learners to identify what is common among all the birds - they should note that all birds have feathers. This is the most distinguishing feature of birds.

Identify characteristics of birds
INSTRUCTIONS:
- Work in groups of three.
- List the identifying characteristics of birds following these steps:
- Do you remember learning about birds in previous years? Work with a different group and brainstorm identifying characteristics of birds. Study the photo of the blue crane above for some clues.
- Use one specific colour to list the characteristics that your group can think of.
- As you learn more about characteristics of birds add these in a different colour to help you remember the new characteristics.
Learner-dependent answers. You should once again ask groups to share their characteristics with the class in order to avoid incorrect characteristics from being included. A typical incorrect characteristic might be that all birds can fly. Point out that many birds, such as penguins and ostriches, cannot fly and remind them that Aristotle used this same classifying technique which proved to be of little use. There are also other animals that can fly which are not birds, such as bats and flies. Learners should note that all birds have beaks, wings and feathers and they lay eggs.
QUESTIONS:
All vertebrates have a backbone with a hollow tube running inside it carrying the nerves.
Just like mammals, birds are also endothermic. What does this tell us about their bodies?
This means that birds can control or regulate their body temperature and can therefore keep warm in very cold climates and keep cool in very hot temperatures.
Learner-dependent answer. Note:Although almost all learners will say that all birds have feathers, not many will be able to identify that birds' feet are covered in scales like those on reptiles. If you are able to go outside to look at some birds, try to see if you can take note of their legs and feet.
Learners are required to evaluate a statement and give an explanation for their evaluation. It is in fact incorrect to say that birds have wings to fly since not all birds' wings are used for flying and many flightless birds exist. Think of the emu, ostrich, penguin, cassowary, kiwi and rhea. A better statement would be: Birds that can fly have wings to do so.
Study the pictures of these flightless birds and compare them with the flying birds in the next column. Use the pictures to write a paragraph explaining the observable differences between flightless and flying birds and why you think these characteristics help some to fly and others not.
|
Flightless Birds |
Flying Birds |
 Ostriches |
 An albatross |
 Penguins. |
 A hummingbird |
The ostrich is very big and has a heavy body with long legs. Its long legs help it to run fast on land. It has wings, but its wings are small in comparison to its big heavy body. The albatross is also a big bird but it has a very large wing span relative to its body. The feathers in the albatross are also small and lie close together to help the bird to fly. Whereas the ostrich has many feathers, but they are big and loose and will not catch the updraft of the wind. The penguin also has a body shape which is not designed to help it fly, but rather to swim. It has short, stubby wings, which are not strong enough to lift it off the ground, but are useful for swimming. It is quite fat and heavy, but this helps to keep it warm in the water. The hummingbird is very light and has small wings which beat extremely fast, allowing it to fly and hover. The hummingbird has wings designed to flap quickly in the wind as they are narrow and light, while the penguin has fatter wings shaped like a paddle which are rather used for swimming.
An application for a smart phone which helps you to identify all birds in South Africa. http://www.sasolbirds.co.za/mobile-app.php
Mammals


Identify characteristics of mammals
INSTRUCTIONS:
- Work in groups of three to four.
- You might have learnt about mammals in previous years. Work with your group to brainstorm as many identifying characteristics of mammals that you can think of. Study the diagram of the lion above for some clues.
-
List the characteristics that you can identify in the space below using one specific colour.
-
As you learn more about mammals, add what you have learnt to this list in a different colour. This will then provide a summary on mammals when you have completed the section.
Learner-dependent answers. Note:After learners have generated their lists, you should ask groups to share their characteristics with the rest of the class in order to insure that no false characteristics are included (although these would provide a foundation for discussion as to why they are not identifying characteristics for instance). Some characteristics that learners might identify are: warm-blooded (endothermic), four limbs, sexual reproduction, live young, hair on bodies.
Mammals are vertebrates meaning they have a backbone. Almost all mammals are endothermic. This means they are also able to maintain (keep) their body temperature at a constant level.
The Naked Mole Rat has lost the ability to regulate its body temperature while other mole rats have weakened abilities to do this since they live underground in areas where the temperatures are generally very stable.
'Thermic' means to do with temperature and 'endo' means inside, so mammals are endothermic as they can regulate their body temperature from the inside.
Mammals give birth to live young which are fed milk. The milk is produced by the mother's mammary glands (in the teats or breasts). Mammals also have hair on their bodies. This varies greatly between mammals. Mammals also have teeth that look different in different parts of the mouth.


All mammals breathe using lungs. Many mammals therefore live on land. Those mammals that do live in water, like whales and dolphins, have to come to the surface of the water to breathe.

Whales and dolphins are born with a layer of hair that gradually thins out as they grow older and eventually disappears. Why do you think they lose their hair?
While the larger cats (lion and leopard) prefer to hunt at night to avoid overheating, cheetah hunt in the middle of the day. There is then less chance of them losing their catch to the larger cats.
Why are there no giant mammals? (video)
Now that we have studied the five main classes of vertebrates it is easy to compare them!
Comparing vertebrates
INSTRUCTIONS:
Use the table below to compare the vertebrates shown in the photos based on the features in the first column.
|
Tortoise  |
Chimpanzee  |
Frog  |
Guinea fowl  |
Goldfish  |
|
|
Class |
|||||
|
Skin covering |
|||||
|
How babies are born |
|||||
|
Habitat |
|||||
|
Ectothermic or Endothermic |
|||||
|
Distinguishing features |
|
Tortoise  |
Chimpanzee  |
Frog  |
 |
 |
|
|
Class |
Reptile |
Mammals |
Amphibian |
Birds |
Fish |
|
Skin covering |
dry, scales |
Hair or fur |
smooth, slippery |
feathers |
slimy, scales |
|
How babies are born |
lays eggs |
live birth |
lays eggs |
lays eggs |
lays eggs |
|
Habitat |
on land |
on land |
in water when young, on land when older |
on land |
in water |
|
Ectothermic or Endothermic |
ectothermic |
endothermic |
ectothermic |
endothermic |
ectothermic |
|
Distinguishing features |
Scales and lay eggs |
Young drink milk from the mammary glands of the mother and have fur |
Live first stage in water, then on land |
Have feathers. |
Live only in water, have fins, scales and gills. |
Now that we have looked at all the classes of vertebrates, let's have a look at the invertebrates.
Invertebrates
- antennae
- arthropod
- exoskeleton
- jointed (segmented) limbs
What should you look out for when you have to decide if an animal is an invertebrate?
- All invertebrates lack a backbone. They either have a hard outer shell or a fluid-filled structure that acts as a skeleton (for example jellyfish and slugs).
- All invertebrates are ectothermic.
Did you know that 97% of the animals on Earth are invertebrates? Due to the huge diversity in the invertebrates, it can sometimes make classifying them a bit tricky. The invertebrates are divided into several phyla. Some of the invertebrate phyla are:
- Molluscs (for example snails and octopuses)
- Arthropods (for example insects, spiders and crabs)
- Echinoderms (for example sea urchins and starfish)
- Cnidaria (for example jellyfish)
- Porifera (sponges)
- Annelids (segmented worms)
- Platyhelminthes (flatworms)
There are some other phyla too. As you can see, the invertebrates are a very large and diverse group of animals. We are mostly going to focus on the two phyla Arthropods and Molluscs.
Find out more about the other phyla of invertebrates http://www.earthlife.net/inverts/an-phyla.html
The word arthropod comes from two greek words arthron meaning 'joint' and podos meaning 'leg', so together it means 'jointed legs'. Arthropods have an exoskeleton and they have jointed (segmented) limbs.
Let's now find out more about Arthropods!
Arthropods
The invertebrates that fall into the phylum arthropoda, all have a hard outer covering called an exoskeleton. The exoskeleton protects the animal and provides a place for its muscles to attach and function.
Classifying arthropods
If possible, collect different arthropods in a terrarium and have learners study them with magnifying glasses as they work through the activity. However, photos have been provided if this is not possible. Learners can still be encouraged to study different arthropods in the school premises as they work through the activities. If the school permits this, ask learners to walk around school taking photos with cell phones or cameras of arthropods to share with the class. If the school has access to an interactive whiteboard, put these photos up and use these to complete this activity.
INSTRUCTIONS:
- Study the photos of different arthropods below.
- Answer the question that follow.










The mosquito is responsible for more human deaths each year than any other animal on earth! Malaria is carried by mosquitoes and passed to humans when an infected female bites.
Centipedes are venomous and have a very painful sting!
QUESTIONS:
-
Describe how the bodies of the different arthropods look and if you could touch it, what do you think it would feel like?
-
Do you think their bodies would be warm or cold?
- They have hard shell-like bodies that look sturdy and inflexible; it would possibly feel hard and would crunch if broken.
- Their bodies would feel similar to the temperature of their environment.
- Describe how the legs of the different arthropods look in general.
- How are the legs able to bend?
-
One way to classify an arthropod is to count its legs and to group these animals according to this. Count the legs on each of these arthropods and write their names in the appropriate column below to see to which group they belong.
Insects = 6 legs
Arachnids = 8 legs
Crustaceans = 10 legs
Diplopoda and Chilopoda = many legs
- The legs are made of different parts that are joined together and are mostly covered in the same hard exoskeleton as the body.
- Where the pieces of the leg come together they form a flexible joint that allows the leg to bend and move.
-
The learners' tables must look like this:
Insects = 6 legs
Arachnids = 8 legs
Crustaceans = 10 legs
Diplopoda and Chilopoda = many legs
Dung beetle
Grasshopper
Butterfly
Spider
Scorpion
Crab
Prawn
Crayfish
Centipede
Millipede
It sheds the hard exoskeleton (outer skeleton) in a process called moulting.
Most crustaceans are aquatic, either marine or freshwater. The other classes mostly live on land, although many live near water.
Insects have wings. No, not all insects have wings.

The coconut crab (Birgus Latro) is the largest land-living arthropod on Earth and weighs up to 4 kg! It can crack whole coconuts with its pincers.
Molluscs
Molluscs are a very diverse phylum of invertebrates. They have a huge range in body shapes and sizes. Molluscs are often given a general description which is that they have internal or external shells and a single muscular 'foot'. However, there are lots of molluscs which do not strictly fit this description, such as slugs.
Mollusc is Latin for "soft" which refers to the soft bodies of molluscs.
The group of molluscs include snails, squid, octopuses, periwinkles, abalone, mussels, oysters and other soft-bodied animals.
Video on nudibranch sea slugs








Video on Cuttlefish: The chameleons of the sea
Observing molluscs
INSTRUCTIONS:
- Carefully study the above photos of different animals that form part of the phylum mollusca.
- Answer the following questions.
QUESTIONS:
Molluscs have soft bodies, which are often slimy to touch. Most molluscs have one or two hard shells to protect their bodies, sometimes the shell is inside, like that of the cuttlefish, squid and octopus. Molluscs live in moist environments, mostly in the sea.
They would dry out and die.
Learner-dependent answers - they might say that they found more snails in low-traffic areas and in shady, less-exposed places, often where it is damp or under foliage.
If possible, collect a few snails to study in class. If you have a glass terrarium or an old aquarium, keep the snails in there, or else keep a few in large clean glass jars.
Note:In the last section of this term's work learners are going to study variation and survival of the strongest / fittest. They will need snails for that activity too, so if possible keep the snails from this activity for then. Just make sure the lid is securely shut on the terrarium as snails will escape and arriving to a slime-covered desk / class before school is no fun at all!
Carefully study their bodies and especially their long, slimy foot.
-
What do you think the slime is used for?
-
Describe how the snail moves.
-
How many tentacles (antennae) does the snail have? What do you think these are used for?
-
What markings are on the shell? Why do you think the shell is marked in this particular way?
-
Try and see if you can find male and female snails. What conclusion can you draw from this.

- As the snail moves it leaves behind a trail of slime to make it easier for the rest of the body to slide or glide over. This allows it to move easily over any type of surface.
- Muscles in the foot of the snail contract and relax causing it to move along.
- Snails can have one or two pairs of tentacles (antennae) depending on the species (however they may be retracted). One pair of light-sensitive eyes are usually on the longest pair of antennae and the other pair of antennae are used for smell and touch.
- The snails' shells are marked to blend into their environment and to break the outline of their shape to help to camouflage them.
- Learners should say that they cannot see any difference and should be able to conclude that either they only collected one sex or that snails do not have a male and a female snail (which is in fact the truth). Most land snails have both male and female parts. They are hermaphrodites. When they meet with other snails during mating they will both conceive and lay eggs, so double the number of offspring are formed.
Make a drawing of a snail. Include the following labels: hard shell, foot, head, mouth, tentacle, eyespot.
Learner-dependent answer
Diversity of plants
- bulb
- rhizome
- root
- seeds
- shoot
- spore
- stem
- symbiotic
In this section we will take a closer look at the organisms in the plant kingdom. So how do we classify plants?
This section guides learners as they investigate the plant kingdom by grouping plants with seeds and those without seeds into two main groups.
Classifying plants
As an introduction to the diversity of plants, you can do a short walk around your school, aimed at developing a greater awareness of the plants in and around the school, and specifically those that produce seeds and those that do not. Also encourage learners to take note of leaf shape, size, flowers, etc.
We can easily compare plants based on their characteristics. For example, their leaf size and shape, whether there are flowers or not and how the petals look, the length and depth of the roots and the type of root system, and many others.
If you would like to join and become a research scientist yourself, visit the iSpot website http://www.ispot.org.za/
One particularly useful way is grouping plants according to how they reproduce sexually. If we group plants based on the way that they sexually reproduce we can quickly see two distinct groups:
-
Plants with seeds
- Seedless plants
Plants can also reproduce asexually by making a clone or copy of themselves. In this way new plants can grow from cuttings and tubers (like potatoes), from bulbs and rhizomes, or from shoots and side branches.
Plants that do not produce seeds include ferns, mosses and algae. These plants produce spores. The spores often develop in structures found on the underside of the leaves or fronds. The spores grow into new plants.
If possible, pick some fern fronds to bring to school. You can also look for moss growing in moist environments, such as under a dripping tap and pick some to bring to class. You can then show learners the spore forming structures on the underside of the fern leaves.

Ferns have been around for about 400 million years. That is even older than dinosaurs, and they are still living on Earth today.
The following photo shows a close-up of the underside of a fern leaf. Can you see the clusters of capsule-shaped structures that form the tiny spores?
A small hand lens is useful to examine the underside of the fern leaves (if available).

The close-up photo on the right shows a moss sporophyte. This contains the spores of the moss plant.


Do you know what lichen is? You often see it growing on rocks and tree trunks. Do you think lichen is a plant? Look at the photos of lichen below.


Lichen actually consist of two different organisms growing together! A fungus and a green alga grow together in a symbiotic relationship. The fungus absorbs water from the environment and provides the algae with an environment to grow in. The green algae photosynthesizes, providing food for the itself and the fungus. Why can the fungus not make its own food? Is the fungus a plant? Can you come up with a definition for a symbiotic relationship? Discuss this with your class and take some notes.
Alga is singular and algae is plural!
Discuss this with your learners. Encourage them to take notes in the margins of their workbooks. A fungus is not a plant. Fungi are one of the five kingdoms of organisms. Fungi do not contain chlorophyll and cannot photosynthesize. They therefore need to obtain their nutrients from elsewhere. Ask your learners what they think a symbiotic relationship is. A symbiotic relationship is one in which one or both organisms benefit. A parasite is something which lives off another organism in some way and harms that organism. The relationship benefits the parasite, but not the host. It is not mutually beneficial. On the other hand, the honey bird and the badger, which learners may have learned about in Gr 6, both benefit from their relationship. It is a mutually beneficial symbiotic relationship. Start by asking learners if the relationship between the fungus and the alga is beneficial to one or both of them? Both the algae and fungus benefit from the relationship. Therefore it is a mutually beneficial symbiotic relationship.
The other group of plants produces seeds. These plants can either produce seeds in flowers or they can produce seeds in cones. Most plants that you see around you, produce seeds. Plants that produce seeds in flowers are called angiosperms and plants that produce seeds in cones are called gymnosperms.


We can therefore classify plants as follows:

Come back to complete this diagram once we have learned more about angiosperms.
The words to fill in on the diagram are monocotyledon for one cotyledon and dicotyledon for two cotyledons.
Seed-bearing plants
- cotyledon
- dicotyledon
- herbaceous
- leaf vein
- monocotyledon
- tap root
Gymnosperms
Have you ever seen a living prehistoric plant? If you thought about it, you probably have without even realising it!
In South Africa we have plants called cycads that are often referred to as 'living fossils'. Cycads grew in great numbers during the Jurassic period. They have not been around for as long as ferns and algae, but they have been on Earth for longer than all flowering plants. Flowering plants (angiosperms) evolved after gymnosperms.
South Africa is considered a diversity hotspot for cycads. Along with Australia,Mexico, China and Vietnam, we account for 70% of Earth's cycad species.


http://www.plantapalm.com/vce/toc.htm for more information on cycads.
Can you see the large cones in the photo of the cycad above? They are in the centre of the plant. The cones are made up of many individual seeds. Look at the following close up images of cones.


The word gymnosperm means 'naked seed'. Gymnosperms are considered to have naked seeds as the seeds are not covered in a fruit, like we will see in angiosperm plants.
Another gymnosperm which is native to South Africa, and grown a lot in the Cape is the Mountain Cypress, as shown in the photo. They grow especially well at high altitudes, such as in the Cederberg Mountains.

There are several species of gymnosperms which are not indigenous to South Africa. What does this mean? Let's find out.
Invasive plants in South Africa
INSTRUCTIONS:
- Study the following photographs of various gymnosperm plants in South Africa.
- Answer the questions that follow.
- You will need to do some research in books and on the internet.


QUESTIONS :
An indigenous plant is one which occurs naturally in a particular geographical such as South Africa.
An alien species is one which is not indigenous to South Africa, or a particular geographical area. It has been brought in by humans from another part of the world. They are said to be invasive as they invade (take over) the areas in which indigenous plants grow.
They are gymnosperms so they reproduce by making seeds in cones.
Learner-dependent answer. Learners may either disagree or agree. There are many viewpoints on this at the moment. Perhaps they feel that this is one area which mountain bikers should be allowed to enjoy as a forest as the rest of Table Mountain is covered in fynbos. Alternatively, they may agree that we need to re-establish the local flora and fauna, and although it may take time for a forest and shade to regrow, it will be better in the long run from an ecological point of view.
Pretoria's Jacaranda trees are an 'alien' problem. (video)
Let's now take a look at the other group of seed-producing plants, angiosperms.
Angiosperms
Angiosperms are flowering plants. They produce flowers which develop into seeds that can grow into new flowering plants. We will learn more about reproduction in angiosperms in the next chapter. Most of the plants that you probably see around you in the gardens are flowering plants.
An idea to introduce this topic is to get sheets of paper and get learners to brainstorm the names of as many flowering plants as possible that they know. As many learners are not that familiar with the names of plants and animals in their area, we encourage teachers to use this to add names of plants as learners get to know them in this section. Encourage learners to review the chart they make and to add to it as they go along. Try and identify as many local examples as possible with your class. This is aimed at showing the diversity of flowering plants in South Africa. You can even cut some flowers to bring in to class.
We can group flowering plants into two major groups:
-
monocotyledons
-
dicotyledons
All the angiosperm plants that we are studying have the following characteristics in common:
- roots
- stems
- leaves
- flowers
- fruits
- seeds
A huge thorn tree does not look anything like a maize plant, yet they are both flowering plants. They both have roots, stems, leaves and their flowers produce seeds. So why can we group the one as a dicotyledon and the other as a monocotyledon? Let's find out!
If possible, bring some examples of monocots and dicots into class for this activity so that learners can study actual examples of the plants. Be sure to include some wind pollinated plants that do not have obvious flowers, as many learners don't realize that grasses form flowers.
Discovering the differences between monocotyledons and dicotyledons
INSTRUCTIONS:
- Study the photos of South African monocotyledons and then dicotyledons.
- Answer the questions which follow about each group.
Monocotyledons:




QUESTIONS:
Learner-dependent answer. The leaves are generally long and narrow. The veins run parallel down the length of the leaves.
Describe the stems. Are they woody stems or green (herbaceous) stems?
The stems are all green, with no wood. They are herbaceous.
Look at the following photos of typical monocotyledonous flowers. Count how many petals are on each flower. What can you generalize about the number of petals (and other flower parts) in monocotyledonous flowers?



The amaryllis flower has six petals, the agapanthus flowers also have six petals, the disa has three petals. We can say that in general, monocotyledonous flowers have parts in multiples of three.
Many of the crops that we grow are monocotyledons, such as maize and sugar cane. Name two others.
Some examples include: wheat, rice, oats, barley, sorghum.
Dicotyledons:




QUESTIONS:
The leaves are varied in shape and size. They are generally broad and the veins form a branching network across the leaves.
The stems are varied, some are green and some are woody, for example in the tree species.
Look at the following photos of typical dicotyledonous flowers. Count how many petals are on each flower. What can you generalize about the number of petals (and other flower parts) in dicotyledonous flowers?




The geranium flowers have ten petals, the plumbago flowers have five petals, the hibiscus flower has five petals, the hydrangea flowers have four petals. We can say the dicotyledons have flowers with parts in multiples of four or five.
Look at the following image which shows the difference between monocotyledonous seeds and dicotyledonous seeds. Monocotyledons have one cotyledon and dicotyledons have two cotyledons.

Learners may be under the impression that the entire mielie pip is the cotyledon.You may want to explain that the little "yellow bit" that can be squeezed out of a maize pip is the cotyledon of the embryonic plant. The rest is just stored food.
Using the information you have discovered in this activity, complete the following table to summarize the differences between monocotyledons and dicotyledons.
|
Monocotyledons |
Dicotyledons |
|
|
Cotyledons |
||
|
Stems |
||
|
Flowers |
|
Monocotyledons |
Dicotyledons |
|
|
Cotyledons |
One |
Two |
|
Stems |
The stems are herbaceous, meaning they do not have much wood, are often green and soft. |
The stems can be herbaceous or woody. |
|
Flowers |
Generally, the flower parts are in multiples of three. |
Generally, the flower parts are in multiples of four or five. |
Hydrangea flowers can tell us about the soil acidity! An acidic soil (pH below 7) will normally produce blue flowers, whereas an alkaline soil (pH above 7) will produce more pink flowers.
The biodiversity of South Africa's fynbos. (video)
Find out which of South Africa's plants are most threatened and closest to extinction http://redlist.sanbi.org/
Summary
- All the plants, animals and microorganisms and their habitats make up the total biodiversity of planet Earth.
- Living organisms are sorted and classified according to their shared characteristics.
- Many scientists have developed different systems to group and classify the living organisms on earth.
- We use a classification system that groups living organisms into five main groups or kingdoms: Bacteria, Protists, Fungi, Plants and Animals
- All living organisms have to perform the seven life processes and the way in which they perform these help us to classify them into different groups, putting plants into one group and animals into another for instance.
- We can divide a kingdom into smaller and smaller groups, in this order: phyla, classes, orders, families, genera and species.
- In the kingdom of animals, we can get two main groups of animals - this with a backbone called vertebrates, and those without a backbone called invertebrates.
- The vertebrates are divided into five groups: Mammals, Birds, Reptiles, Fish and Amphibians.
- The invertebrates make up the largest group of animals and there are many thousands of species. We also divide the invertebrates into different groups or phyla like the arthropods, molluscs, sponges and jellyfish, and many others.
- Arthropods all have a hard exoskeleton and jointed legs, such as insects, arachnids (spiders) and crustaceans (crabs).
- Molluscs have a soft body with or without a shell, such as snails and octopuses.
- In the kingdom of plants we also get two main groups: plants that produce seeds and plants that do not produce seeds but spores.
- Seedless plants produce spores - like ferns and some mosses.
- Seed producing plants can be further divided into angiosperms (seeds in fruit) and gymnosperms (seeds in cones).
- Angiosperms can be further divided into monocotyledons and dicotyledons.
- Monocotyledons have seeds that only have one part or cotyledon. Their stems are herbaceous. The leaves are simple, long and narrow and their flower parts are arranged in multiples of three.
-
Dicotyledons have seeds with two parts or cotyledons from which their tap root grows deep into the soil. Their stems can be woody or herbaceous. The leaves are varied in shape and size and have a network of leaf veins. Flower parts are usually arranged in multiples of four or five.
Concept map
This concept map shows how the concepts in this chapter on Biodiversity link together. Complete the concept map by filling in the five Kingdoms that living things are classified into, and also giving the two major groups of angiosperm plants.
Can you see how the arrows show the direction in which you must "read" the concept map?

Teacher's version: Remember that concept maps are different to mind maps in that concept maps have a hierarchical structure and show how concepts link together using arrows and linking words. Whereas mindmaps generally contain a central topic and individual branches coming out which do not necessarily link together. Mindmaps can also be a useful way of summarizing information and studying, however, we are using concept maps as they help to show linkages, which is very important in science. Help your learners to "read" the concept map by showing them that the arrows show the direction in which concepts progress and are linked to each other.

Revision Questions
Use the following diagram to fill in how we classify organisms. The first 3 have been filled in as we did not discuss domains in this chapter. You will learn more about domains in later grades. [6 marks]


Which two levels of classification do we use to name an organism. What is the correct way to write the scientific name of an organism? [3 marks]
We use the Genus and Species name. The correct name is the Genus must have a capital letter and the species a small letter and it is in italics if typed or underlined if handwritten.
As more animals were being discovered it became obvious that many animals can fall into all of these classes and thus it was not a very accurate method of classification.
Use the following space to draw a classification diagram of the animal kingdom. It has been started for you. You only need to include the phyla and classes that we studied in detail. [11 marks]

Learner-dependent answer.
The following gives an example of the animal classification learners could have drawn.

-
The existence of a large number of different kinds of plant and animal species which make a balanced environment. [1 mark]
- The animal kingdom can be divided into two main groups. [2 marks]
- The five classes of vertebrates are: [5 marks]
- The phylum of animals that have a hard exoskeleton. [1 mark]
- The phylum of animals that have a soft body often protected by a shell. [1 mark]
- biodiversity
- vertebrates and invertebrates
- fish, amphibia, reptiles, mammals, birds
- arthropods
- molluscs
- A small percentage of the living organisms on Earth are invertebrates.
- Invertebrate animals do not have a backbone.
- Spiders are examples of arthropods.
- All molluscs have exoskeletons in the form of shells.
- Birds only have feathers as their body covering.
- Endothermic animals need to keep very still when it is cold.
- False - A large percentage of living organisms are invertebrates; OR A small percentage of the living organisms are vertebrates.
- True
- True
- False - Molluscs typically have a hydroskeleton and only some have shells.
- False - Birds have feathers but also have leathery scales covering their legs. (A body covering encompasses the entire body of the animal.)
- False - An advantage of being endothermic is that the animal is able to move when it is very cold unlike cold-ectothermic animals.
Look at the following sentences and underline the one that best describes mammals. [1 mark]
- Mammals are animals that breathe, move, eat, reproduce and excrete.
- Mammals are animals that can regulate their body temperatures.
- Mammals are warm blooded animals that feed their young, have special organs for breathing and a backbone.
- Mammals are warm blooded animals with mammary glands, a hairy body, lungs and a backbone.
- Mammals give birth to live young, can be found living on land and in water, and can sense their environment with well defined smell and touch senses.
- Too broad - all animals should be able to fulfil these if they are alive.
- Too vague - birds and mammals can regulate their body temperatures.
- Too vague - this can easily describe birds as well.
- Learners should underline d.
- Could describe a boa constrictor as well.
Describe how the seeds of angiosperms differ from those produced by the organism in the photo. [2 marks]

Seeds in angiosperms are enclosed in fruit; seeds of gymnosperms are 'naked' or on the cone itself.
Learner-dependent answer
Learners could produce something like the following.

Total [55 marks]
















